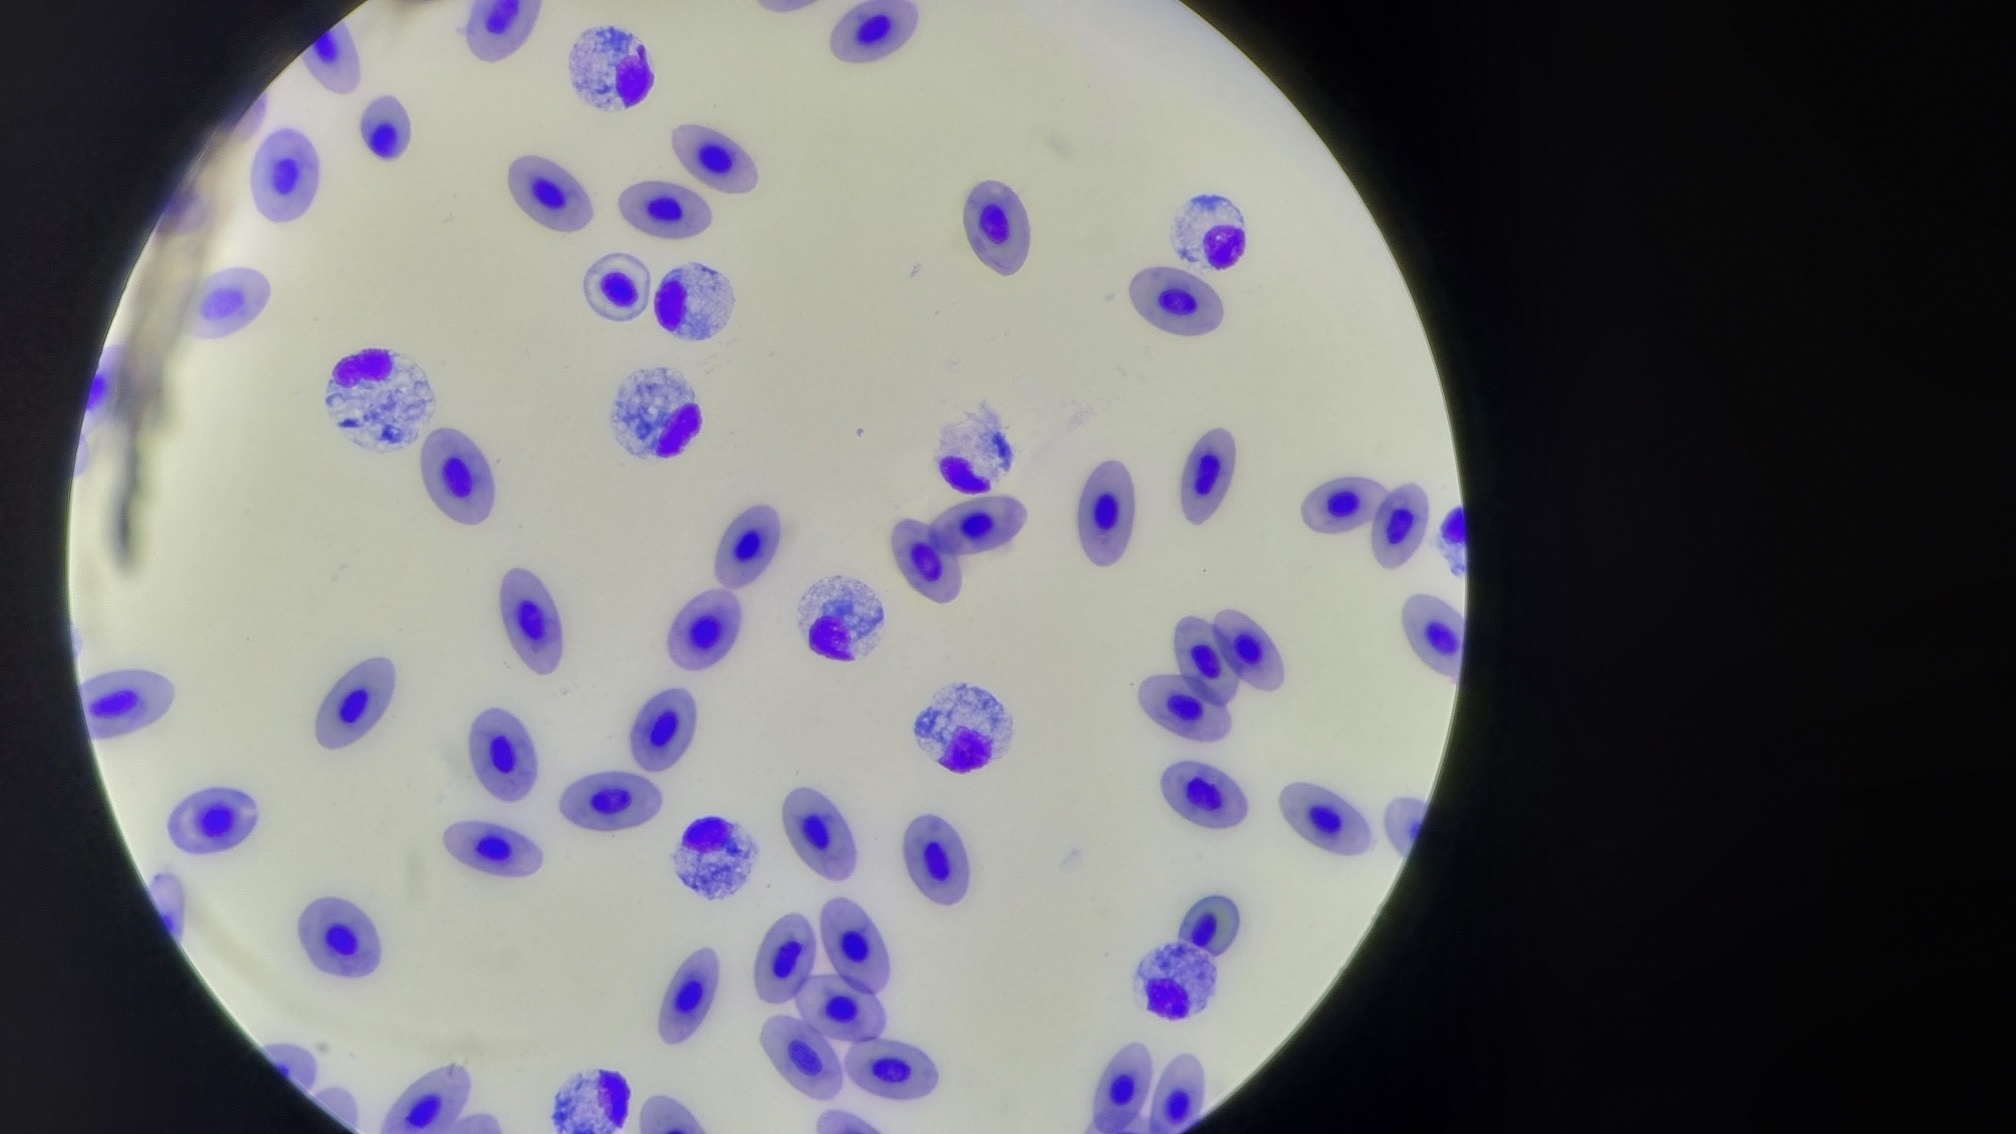
Miniature de la galerie

Recherche

uberall
FishCareVet
Dernière mise à jour : 4/28/23, 10:35 AM
À propos
Dierenarts gespecialiseerd in vissen en diagnostisch aquatisch laboratorium. Enkel op afspraak. Telefonische openingsuren zijn hieronder weergegeven. Buiten deze uren contact graag via onze website.
Infos supplémentaires
Images


Water analysis

Health check

At work


Customer locations

Blood analysis
Questions Fréquemment Posées
Quels jours FishCareVet est-il ouvert?
Ouvert le Lundi, Mardi, Mercredi, Jeudi, Vendredi.
Attention propriétaire d'entreprise!
Enregistrez votre entreprise maintenant et améliorez votre portée mondiale avec iGlobal.
Copié dans le presse-papiers !